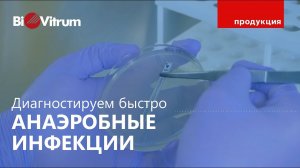
Ускоренная диагностика анаэробных инфекций

6:40
6:40
2024-08-09 15:46

 53:25
53:25

 53:25
53:25
2025-11-24 11:08

 3:40
3:40

 3:40
3:40
2025-09-24 11:18

 49:51
49:51

 49:51
49:51
2024-10-02 15:57

 1:01:35
1:01:35

 1:01:35
1:01:35
2024-09-25 19:21

 2:21:03
2:21:03

 2:21:03
2:21:03
2024-09-29 21:40

 45:46
45:46

 45:46
45:46
2024-09-30 17:31

 1:09:36
1:09:36

 1:09:36
1:09:36
2024-09-25 17:56

 1:14:48
1:14:48

 1:14:48
1:14:48
2024-10-02 15:00

 58:46
58:46

 58:46
58:46
2024-09-27 18:00

 2:02:01
2:02:01

 2:02:01
2:02:01
2024-09-29 23:00

 32:10
32:10

 32:10
32:10
2024-09-30 11:00

 29:05
29:05

 29:05
29:05
2024-09-26 12:57

 1:05:04
1:05:04

 1:05:04
1:05:04
2024-09-30 22:40

 1:25:42
1:25:42

 1:25:42
1:25:42
2024-09-30 20:00

 26:01
26:01

 26:01
26:01
2024-09-26 19:17

 27:00
27:00

 27:00
27:00
2024-10-01 01:30

 46:36
46:36
![Эльдар Агачев - Путник (Премьера клипа 2025)]() 3:14
3:14
![Карина Салагати - Сердце горца (Премьера клипа 2025)]() 3:18
3:18
![Бунёд Бобокулов - Отам-онам (Премьера клипа 2025)]() 4:00
4:00
![SHAXO - Пьяница (Премьера клипа 2025)]() 3:32
3:32
![Владимир Ждамиров, Игорь Кибирев - Тик так (Премьера 2025)]() 3:30
3:30
![АКУЛИЧ - Красные глаза (Премьера клипа 2025)]() 2:13
2:13
![Рузибек Кодиров - Бинафша (Премьера клипа 2025)]() 3:31
3:31
![Шавкат Зулфикор & Нурзида Исаева - Одамнинг ёмони ёмон буларкан (Премьера клипа 2025)]() 8:21
8:21
![Инна Вальтер - Татарский взгляд (Премьера клипа 2025)]() 3:14
3:14
![Дана Лахова - Только нам выбирать (Премьера клипа 2025)]() 2:21
2:21
![Азамат Исенгазин - Мой свет (Премьера 2025)]() 2:47
2:47
![NAIMAN - Плакала (Премьера клипа 2025)]() 2:21
2:21
![Леся Кир - Альфонс (Премьера клипа 2025)]() 3:23
3:23
![Зульфия Чотчаева - Холодное сердце (Премьера клипа 2025)]() 2:52
2:52
![Zhamil Turan - Губки не целованы (Премьера клипа 2025)]() 2:37
2:37
![KhaliF - Я розы тебе принес (Премьера клипа 2025)]() 2:06
2:06
![Отабек Муминов - Кетябсан (Премьера клипа 2025)]() 3:17
3:17
![Ozoda - Chamadon (Official Video 2025)]() 5:23
5:23
![ZIMMA - Город Тает (Премьера клипа 2025)]() 2:30
2:30
![Хушнуд - Бевафо ёр (Премьера клипа 2025)]() 5:39
5:39
![Гедда | Hedda (2025)]() 1:48:23
1:48:23
![Рок-н-рольщик | RocknRolla (2008) (Гоблин)]() 1:54:23
1:54:23
![Пойман с поличным | Caught Stealing (2025)]() 1:46:45
1:46:45
![Свайпнуть | Swiped (2025)]() 1:50:35
1:50:35
![Порочный круг | Vicious (2025)]() 1:42:30
1:42:30
![Богомол | Samagwi (2025)]() 1:53:29
1:53:29
![Вальсируя с Брандо | Waltzing with Brando (2024)]() 1:44:15
1:44:15
![Убойная суббота | Playdate (2025)]() 1:34:35
1:34:35
![Безжалостная | Stone Cold Fox (2025)]() 1:25:31
1:25:31
![Баллада о маленьком игроке | Ballad of a Small Player (2025)]() 1:42:60
1:42:60
![Святые из Бундока | The Boondock Saints (1999) (Гоблин)]() 1:48:30
1:48:30
![Большой Лебовски | The Big Lebowski (1998) (Гоблин)]() 1:56:59
1:56:59
![Супруги Роуз | The Roses (2025)]() 1:45:29
1:45:29
![Мужчина у меня в подвале | The Man in My Basement (2025)]() 1:54:48
1:54:48
![Супергеройское кино | Superhero Movie (2008)]() 1:22:33
1:22:33
![Битва за битвой | One Battle After Another (2025)]() 2:41:45
2:41:45
![Французский любовник | French Lover (2025)]() 2:02:20
2:02:20
![Фантастическая четвёрка: Первые шаги | The Fantastic Four: First Steps (2025)]() 1:54:40
1:54:40
![Только ты | All of You (2025)]() 1:38:22
1:38:22
![Диспетчер | Relay (2025)]() 1:51:56
1:51:56
![Карли – искательница приключений. Древнее королевство]() 13:00
13:00
![Ну, погоди! Каникулы]() 7:09
7:09
![Отважные мишки]() 13:00
13:00
![Врумиз. 1 сезон]() 13:10
13:10
![Новое ПРОСТОКВАШИНО]() 6:30
6:30
![Игрушечный полицейский Сезон 1]() 7:19
7:19
![Команда Дино. Исследователи Сезон 1]() 13:10
13:10
![Роботы-пожарные]() 12:31
12:31
![МиниФорс Сезон 1]() 13:12
13:12
![Панда и петушок Лука]() 12:12
12:12
![Школьный автобус Гордон]() 12:34
12:34
![Рэй и пожарный патруль Сезон 1]() 13:27
13:27
![Команда Дино Сезон 2]() 12:31
12:31
![Тёплая анимация | Новая авторская анимация Союзмультфильма]() 10:46
10:46
![Монсики]() 6:30
6:30
![Умка]() 7:11
7:11
![Шахерезада. Нерассказанные истории Сезон 1]() 23:53
23:53
![Зебра в клеточку]() 6:30
6:30
![Люк - путешественник во времени]() 1:19:50
1:19:50
![Таинственные золотые города]() 23:04
23:04

 46:36
46:36Скачать Видео с Рутуба / RuTube
| 256x144 | ||
| 432x232 | ||
| 640x360 | ||
| 856x480 | ||
| 1280x720 |
 3:14
3:14
2025-11-12 12:52
 3:18
3:18
2025-11-19 11:48
 4:00
4:00
2025-11-21 13:29
 3:32
3:32
2025-11-18 12:49
 3:30
3:30
2025-11-13 11:12
 2:13
2:13
2025-11-15 12:35
 3:31
3:31
2025-11-15 12:51
 8:21
8:21
2025-11-17 14:27
 3:14
3:14
2025-11-18 11:36
 2:21
2:21
2025-11-25 10:43
 2:47
2:47
2025-11-19 11:44
 2:21
2:21
2025-11-18 12:25
 3:23
3:23
2025-11-19 11:51
 2:52
2:52
2025-11-18 11:48
 2:37
2:37
2025-11-13 11:00
 2:06
2:06
2025-11-11 18:00
 3:17
3:17
2025-11-15 12:47
 5:23
5:23
2025-11-21 13:15
 2:30
2:30
2025-11-21 13:20
 5:39
5:39
2025-11-23 13:40
0/0
 1:48:23
1:48:23
2025-11-05 19:47
 1:54:23
1:54:23
2025-09-23 22:53
 1:46:45
1:46:45
2025-10-02 20:45
 1:50:35
1:50:35
2025-09-24 10:48
 1:42:30
1:42:30
2025-10-14 20:27
 1:53:29
1:53:29
2025-10-01 12:06
 1:44:15
1:44:15
2025-11-07 20:19
 1:34:35
1:34:35
2025-11-19 10:39
 1:25:31
1:25:31
2025-11-10 21:11
 1:42:60
1:42:60
2025-10-31 10:53
 1:48:30
1:48:30
2025-09-23 22:53
 1:56:59
1:56:59
2025-09-23 22:53
 1:45:29
1:45:29
2025-10-23 18:26
 1:54:48
1:54:48
2025-10-01 15:17
 1:22:33
1:22:33
2025-11-21 14:16
 2:41:45
2:41:45
2025-11-14 13:17
 2:02:20
2:02:20
2025-10-01 12:06
 1:54:40
1:54:40
2025-09-24 11:35
 1:38:22
1:38:22
2025-10-01 12:16
 1:51:56
1:51:56
2025-09-24 11:35
0/0
 13:00
13:00
2024-11-28 16:19
 7:09
7:09
2025-08-19 17:20
 13:00
13:00
2024-11-29 13:39
2021-09-24 16:00
 6:30
6:30
2018-04-03 10:35
2021-09-22 21:03
2021-09-22 22:45
2021-09-23 00:12
2021-09-23 00:15
 12:12
12:12
2024-11-29 14:21
 12:34
12:34
2024-12-02 14:42
2021-09-22 23:51
2021-09-22 22:40
 10:46
10:46
2022-06-07 11:02
 6:30
6:30
2022-03-29 19:16
 7:11
7:11
2025-01-13 11:05
2021-09-22 23:25
 6:30
6:30
2022-03-31 13:09
 1:19:50
1:19:50
2024-12-17 16:00
 23:04
23:04
2025-01-09 17:26
0/0

